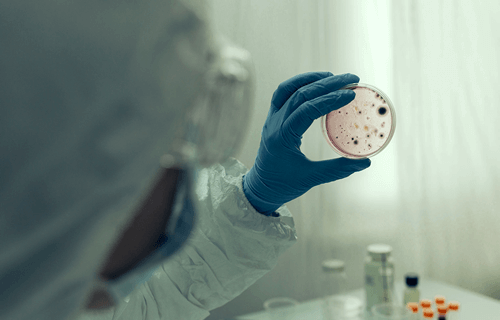
Infectologia – MedDoctor

Especialista da Santa Casa de Bragança Paulista fala sobre os desafios da profissão
Especialidade reconhecida desde o final do século 19, quando graves epidemias assolavam o Brasil, os infectologistas são profissionais dedicados ao tratamento de pacientes afetados por uma ampla gama de infecções, incluindo aquelas causadas por vírus, bactérias, fungos ou parasitas. Seu papel é fundamental na defesa da saúde pública, concentrando-se na prevenção e tratamento eficaz dessas doenças infecciosas.
No dia 11 de abril é celebrado o Dia do Infectologista. A data foi instituída em 2005 pela Sociedade Brasileira de Infectologia (SBI), em homenagem ao nascimento do médico sanitarista Emilio Ribas, que se destacou no combate da febre amarela, provando que a transmissão da doença se dava através da picada do mosquito Aedes Aegypti.
De acordo com dados da pesquisa Demografia Médica de 2023, o Brasil tem um infectologista para cada 485.169 brasileiros. E a área tem crescido significativamente nos últimos anos. Em 2012, havia 2.591 médicos com essa especialidade registrados, enquanto em 2023 esse número aumentou para 4.736 – crescimento de aproximadamente 82,8%.
Este aumento reflete a crescente necessidade de especialistas capacitados para lidar com desafios emergentes em saúde pública, como a pandemias de Covid-19 ou a atual epidemia de dengue enfrentada em muitas regiões do Brasil, bem como a complexidade de outras doenças infecciosas.
“Após a pandemia do coronavírus em 2020, houve uma necessidade crítica de mais profissionais especializados como uma resposta a emergências de saúde pública. Estivemos diretamente envolvidos no diagnóstico, tratamento e controle da propagação da Covid-19, orientando protocolos, políticas de saúde pública e fornecendo cuidados especializados aos pacientes infectados”, declarou o infectologista da Santa Casa de Bragança Paulista, Dr. Fellipe Godoy.
A importância da especialidade em infectologia tem sido reiterada com a chegada da epidemia de dengue em algumas regiões do Brasil. Os médicos infectologistas desempenham um papel crucial na conscientização e prevenção dessa doença, ressaltando a necessidade de eliminar os criadouros do mosquito Aedes aegypti e promovendo o uso de medidas individuais de proteção. Além disso, enfatizam a importância do diagnóstico precoce e do tratamento adequado para evitar complicações graves e possíveis óbitos, contribuindo assim para a redução da incidência da doença.
No Brasil, assim como em países de baixa e média renda, há o desafio duplo de lidar com o aumento dos casos de doenças não transmissíveis, como diabetes e doenças cardiovasculares, ao mesmo tempo em que ainda enfrentamos uma alta incidência de doenças infecciosas. Como país tropical, o Brasil está particularmente suscetível a uma variedade de doenças infecciosas, desde aquelas transmitidas por vetores, como malária e febre amarela, até infecções bacterianas e virais.
“O Brasil tem um clima favorável à proliferação de diversos agentes infecciosos, o que aumenta a importância da educação pública sobre medidas preventivas, como o controle de vetores e a promoção da higiene, para combater essas doenças infecciosas que ainda representam um desafio significativo para a saúde pública brasileira”, explica o especialista da Santa Casa de Bragança Paulista.
Sobre o Complexo Hospitalar Santa Casa de Bragança Paulista
Fundada em 31 de agosto de 1874, o Complexo Hospitalar Santa Casa de Bragança Paulista é um hospital geral, filantrópico, de atendimento secundário e referência na baixa e médica complexidade. Atualmente, possui um quadro com aproximadamente 1.200 profissionais e 350 médicos. A unidade atende a população composta por 520 mil pessoas, que residem nos 11 municípios da região bragantina.
Dica de entrevista
Assessoria de Imprensa da Santa Casa de Bragança Paulista:
Predicado Comunicação
Diego Borges Brito – diego@predicado.com.br (11) 9 1119-2911 WhatsApp
Vanessa de Oliveira – vanessa@predicado.com.br (11) 9 7529-0140 WhatsApp
Carolina Fagnani – carolina@predicado.com.br (11) 9 9144-5585 WhatsApp
Viviane Bucci – viviane@predicado.com.br (11) 9 3072-8305 WhatsApp


